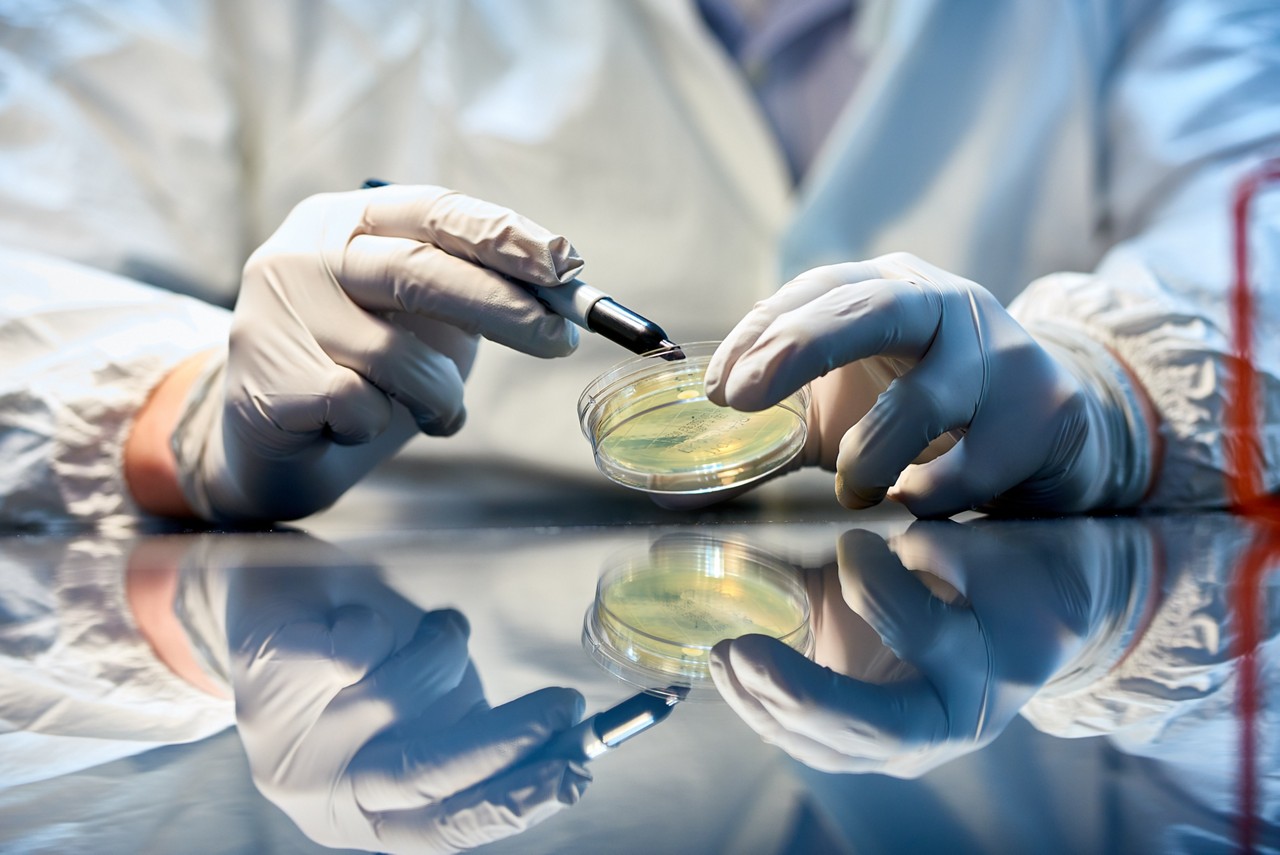
Viral vector manufacturing and development capabilities at Plainville facility

Plainville, Massachusetts, USA
Viral vector development and manufacturing facility
Our state-of-the-art Plainville facility delivers comprehensive sterile fill-finish and viral vector services, from process development through commercial manufacturing. With exceptional capacity and capabilities, we are fully equipped to meet market demands.
Spanning 290,000 square feet, the site adds additional North American sterile fill-finish development services, with two lines dedicated to final drug product production. It also supports the manufacturing of viral vectors for both clinical and commercial use.
Under one roof, the facility provides process and analytical development, characterization, validation, and clinical and commercial manufacturing. This integrated offering eliminates the need for costly and time-consuming facility-to-facility technology transfers.
Strategically designed for growth, the site can seamlessly accommodate future expansions up to 400,000 square feet, ensuring we continue to meet our clients’ ever-evolving needs.

Key Capabilities:
- Flexible facility designs capable of supporting both adherent and suspension (up to 2000L stirred-tank bioreactors) processes
- Bioprocess sciences lab for process/analytical development, characterization, and scale-up to 2000L
- 11 drug substance suites for viral vector production and purification
- 2 fill finish suites for final drug product production with up to 5,000 vial capacity
- Manufacturing support areas for solution prep and component prep
- Quality control labs to support on-site bioanalytical testing needs
To learn more about this location, download the site capabilities factsheet.
Helpful Resources

Brochure
PDS Steriles Capabilities: US- & EU-based facilities
State-of-the-art steriles PDS services
View Brochure
Blog post
Viral vector commercialization – Part 3: Specialized regulatory support
Find detailed regulatory considerations when preparing viral vectors for commercialization and best practices to address them.
View Blog Post
